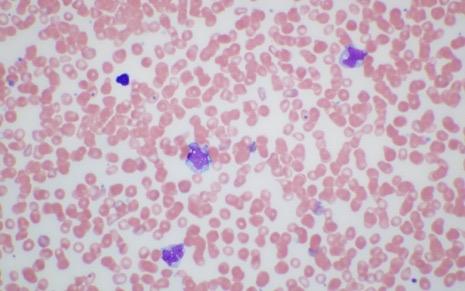
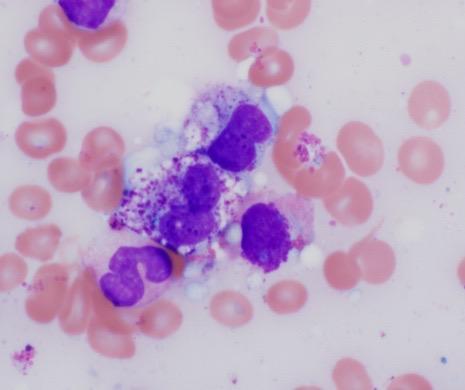

Learning Objectives

• Differentiate nonadvanced and advanced SM subtypes using WHO and ICC diagnostic criteria, symptom profiles, biomarkers, and molecular testing, including high-sensitivity assays
• Explain the pathophysiologic mechanisms of SM, including the role of KIT D816V and other mutations in driving MC proliferation, disease severity, and progression risk
• Interpret the latest clinical trial data and safety/efficacy evidence for FDAapproved and investigational therapies used across the SM spectrum
• Develop individualized, multidisciplinary treatment and monitoring strategies that incorporate disease subtype, symptom burden, shared decision-making, PROs, and coordination across specialties

THE PATHOPHYSIOLOGY AND BURDENS OF SM
Dr. Chernak


SM Is a Rare Clonal MC Disorder

• Bone marrow mastocytosis (BMM)
• Indolent SM (ISM; ≈88% of cases)2
• Smoldering SM (SSM)
• SM with associated hematologic neoplasm (SM-AHN)
• Aggressive SM (ASM)
• Mast cell leukemia (MCL)
• SM affects approximately 1 in 10,000 people4,5
• No apparent gender bias with SM overall6

• Mean age at onset is 46 to 61 years, with a peak in the mid to late 50s7
BM, bone marrow; ECO, extracutaneous organ.
1. Cohen SS, et al. Br J Haematol. 2014;166(4):521-528; 2. Ungerstedt J, et al. Cancers (Basel). 2022;14(16):3942; 3. Mesa RA, et al. Cancer. 2022;128(20):3700-3708; 4. Brockow K. Immunol Clin Allergy North Am. 2014;34(2):283-295; 5. Jørgensen MP, et al. Eur J Epidemiol. 2025;40(1):43-53; 6. Mohsin F, et al. J Clin Oncol. 2025;43(suppl 16):e22559; 7. Sizemore JA, et al. J Am Acad Dermatol. 2025. [Epub ahead of print]; 8. Li JY, et al. Cancers. 2023;15(23):5626.
Key
Pathophysiology Notes

• ≈90% to 95% of patients with NonAdvSM have a KIT D816V mutation, the most common driver mutation of SM
• Constitutive activation of the mutant KIT receptor leads to proliferation and activation of neoplastic MCs
• Progression from NonAdv to AdvSM is impacted by the addition of genetic mutations, MC infiltration, and organ damage
• TKI therapies target underlying SM pathophysiology
Symptoms Associated With SM

MC activators
Allergens, bacteria, cytokines, drugs, fungi, peptides, toxins, viruses
CV system
GI tract
Bone Skin
Constitutional symptoms and hypersensitivity

• Brain fog
• Depression
• Tachycardia
• Hypotension
• Diarrhea
• Nausea
• Vomiting
• Osteopenia
• Osteoporosis
• Osteosclerosis
• Flushing
• Fatigue
• Night sweats


• Headache

CM, BMM, ISM1 SSM, AdvSM1
MC mediators
Granule-derived
• Histamine
• Syncope
• Heparin
Lipid-derived
• PGD2
• Cramping
• Ulceration
• GERD
• Musculoskeletal pain

MC infiltration
• Lymphadenopathy
• Hepatomegaly
• Ascites
• CysLTs Proteases
• Tryptases
• Chymase
• CPA
• PAF
• Itching
• Anaphylaxis
• tPA Cytokines
• TNF
• VEGF
• IL-6
• RANKL
• Liver cirrhosis
• Hypersplenism
• Splenomegaly
• Malabsorption
• Osteolysis
• Pathologic fracture
• Anemia
• Leukopenia
• Thrombocytopenia
• Leukocytosis
• Thrombocytosis

Patients with SM experience an average of 14 SM-related symptoms over the course of their disease.2
CM, cutaneous mastocytosis; CPA, carboxypeptidase A; CV, cardiovascular; CysLT, cysteinyl leukotriene; GERD, gastroesophageal reflux disease; GI, gastrointestinal; IL, interleukin; PAF, platelet activating factor; PGD2, prostaglandin D2; RANKL, receptor activator of nuclear factor-κβ ligand; TNF, tumor necrosis factor; tPA, tissue plasminogen activator; VEGF, vascular endothelial growth factor.
1. Akin C, et al. Nat Rev Dis Primers. 2025;11(1):30; 2. Mesa RA, et al. Cancer. 2022;128(20):3691-3699.
SM and Bone Health
ü Osteoporosis affects up to 30% of patients with SM – Especially young men, who are not commonly affected by osteoporosis
ü Spine osteoporosis and vertebral fractures are hallmarks of SM
ü Bone involvement should be assessed regularly in patients with SM via bone metabolism markers (eg, serum calcium and phosphorus, 25(OH)D, ALP) and/or radiologic assessment of BMD (eg, DEXA, X-rays, CT scan, MRI)

25(OH)D, 25-hydroxyvitamin D; ALP, alkaline phosphatase; BMD, bone mineral density; CT, computed tomography; DEXA, dual-energy X-ray absorptiometry; MRI, magnetic resonance imaging. Degboé Y, et al. Curr Osteoporos Rep. 2025;23(1):10.

Manifestations of SM1

çMC mediator/skin symptom prominent
Skin: pruritus, flushing, hives
GI: nausea, vomiting, diarrhea, abdominal cramps, heartburn
CV: syncope, dizziness, palpitations
Neurologic: memory/cognitive difficulties, depression, headache, sleep disturbance
Prediagnostic SM
Anaphylaxis: (hypotension >> angioedema)
Hymenoptera stings, drugs, food
Bone: osteopenia, osteoporosis, back pain, bone pain
Constitutional: generalized weakness, fatigue, arthralgias, myalgias, sweats, chills
Ensure that organopathy is due to MC infiltration!
• Osteolysis with pathologic fractures
• Lymphadenopathy
• Splenomegaly/Hypersplenism
• Hepatomegaly/Ascites
• Cytopenia
• Malabsorption or protein-losing enteropathy with weight loss
Organopathy prominent è BMM/ISMa SSMb MCL ASM/SM-AHN
Disease burden/aggressiveness è
AML, acute myeloid leukemia; BST, basal serum tryptase. aBMM is marked by absence of skin lesions, BST <125 ng/mL, higher incidence of MC mediator symptoms,2 and tendency to osteopenia/osteoporosis; bSSM is associated with a significantly higher risk of transformation to AML or ASM.2
1. Pardanani A. Am J Hematol. 2023;98(7):1097-1116; 2. National Comprehensive Cancer Network (NCCN). https://www.nccn.org/professionals/physician_gls/pdf/mastocytosis.pdf.

Life Expectancy in Patients With SM
Mayo Clinic, 20241,a Denmark, 20143,f
Mayo Clinic, 20092,e
What Impacts Survival in Patients With SM?

• Anaphylaxis: noted in up to 50% of patients with ISM1,2
– Lifetime prevalence of anaphylaxis in patients with SM is ≈30% to 40%1
• AHNs are most important fatal non–SMrelated pathologies1
– Inferior OS compared to other subtypes of SM without AHN
• Infections with disease-induced and/or therapy-related neutropenia1
• Severe bleeding caused by disease and/or drug-induced thrombocytopenia1

SM Has Significant Negative Impacts on Daily Life and Employment

Delayed Diagnosis Increases Overall Patient Burden
• Median time from symptom onset to diagnosis of SM: 5 to 6 years1,2
– Prior to diagnosis, patients had seen an average of 6 HCPs3
– Diagnostic delays put patients at risk of life-threatening anaphylaxis, organ dysfunction, and severe osteoporosis3,4
– ISM cases frequently experience mediator symptoms of longer duration before diagnosis than is seen with aggressive subtypes5
• Maintain a high index of suspicion for MC disorders when patients present with seemingly unrelated symptoms
• Multidisciplinary management is essential HCP, health care professional.


1. Mesa RA, et al. Cancer. 2022;128(20):3691-3699; 2; Tse KY, et al. J Allergy Clin Immunol. 2024;3(4):100316; 3. Mikkelsen CS, et al. Dermatol Reports. 2014;6(1):5199; 4. Ungerstedt J, et al. Cancers (Basel). 2022;14(16)3942; 5. Sizemore JA, et al. J Am Acad Dermatol. 2025. [Epub ahead of print].
Progression From NonAdvSM to AdvSM1

PROGRESSION WITH TIME
Progression in SM
Progression in AHN
ASMCMML
ISMMDS ISMCMML ASMMPN
Progression in SM
No Progression in AHN
Progression in SM
No Progression in AHN
No Progression in SM
No Progression in AHN
Progression in SM
Progression in SM
No Progression in AHN
Progression in SM
Progression in AHN ISM-MDS, ISM associated with myelodysplastic syndrome; ASM -MPN, ASM associated with myeloproliferative neoplasm. 1. Ustun C, et al. Blood Adv. 2025;9(9):2048-2062; 2. Valent P, et al. J Allergy Clin Immunol Pract. 2022;10(8):1999-2012.
No Progression in AHN
No Progression in SM
No Progression in AHN
CASE 1: Diagnosing a Classical Case of ISM


Dr. Giannetti


• 42-year-old woman
• Recent episode of anaphylaxis to a wasp sting, resulting in ED visit
– BST at PCP follow-up,
25 ng/mL
Christina Allergist visit

• 2- to 3-year history of episodic flushing, fatigue, and recurrent abdominal bloating and diarrhea

• Presenting symptoms today
Maculopapular pigmented skin lesions, Darier’s sign positive


When to Suspect SM
ü Anaphylaxis to insect venom1
ü History of hypotensive anaphylaxis, especially if associated with baseline or event-related tryptase increases2
ü History of hypotensive episodes resulting in presyncope or syncope + absence of urticaria and angioedema + elevated BST level2
History of flushing, itching, and abdominal pain2
2


Blood Work
• CBC/Diff
• CMP
• BST

SM Diagnostic Tests
Genetics


Morphology
• Blood smear
• BM aspirate smear
• BM biopsy


• High-sensitivity KIT D816V mutation analysis (ddPCR)
• Tryptase genotype (HαT)
• Myeloid gene panel (highly recommended)
• Screen for PDGFRα/β rearrangements if eosinophilia is present and KIT D816V is negative







MC Immunophenotype
• Flow cytometry (CD2, CD25, CD34, CD117, CD30)
• IHC (tryptase, CD25, CD117, CD30)



Note any prior history of anaphylaxis and other symptoms of MC activation.
CBC/Diff, complete blood count with differential; CMP, comprehensive metabolic panel; H , platelet derived growth factor receptor alpha/beta. NCCN. https://www.nccn.org/professionals/physician_gls/pdf/mastocytosis.pdf.

Major and Minor Diagnostic Criteria



Serum tryptase level >20 ng/mL (in the case of known HαT, tryptase levels should be adjusted)

KIT D816V (or any other mutation causing ligand-independent activation of KIT)

>25% of MC are immature or atypical in BM smears or spindle-shaped in MC infiltrates detected in sections of BM or ECO
CD2 and/or CD25 and/or CD30 detected on MCs in BM, blood, or other ECO
aThe ICC defines the major criterion as multifocal infiltrates of MCs that are tryptase+ and/or CD117+ . Arber DA, et al. Blood. 2022;140(11):1200-1228; Khoury JD, et al. Leukemia. 2022;36(7):1703-1719; NCCN. https://www.nccn.org/professionals/physician_gls/pdf/mastocytosis.pdf.
Images courtesy of Tracy George, MD, and Anton Rets, MD, PhD.
KIT D816V Is Often Present at Low Allele Frequency

aN=39 patients enrolled in part 1 of PIONEER with a confirmed diagnosis of ISM and moderate to severe symptoms. George T, et al. Blood. 2020;136(suppl 1):7-8.
Christina
Laboratory Testing Results

• BST: 25 ng/mL
• CBC/Diff: normal
• CMP: normal

• PB: KIT D816V+; VAF: 0.09%
• Biopsy of skin lesions: increased number of dermal CD117+/tryptase+ MCs
• Colonoscopy results: few MC clusters Skin MCs






Decision to Perform BM Biopsy in an Adult With Suspected SM
YES

Perform
• Serum tryptase
• CBC/Diff

Does the patient have skin lesions consistent with MPCM/UP?



• High-sensitivity assay for KIT D816V mutational analysis on PB (if available)









Does the patient experience presyncope, syncope, signs of recurrent mediator-related symptoms, anaphylaxis, unexplained osteoporosis? Perform BM biopsy
Perform high-sensitivity assay for KIT D816V mutational analysis on PB (if available)





Perform BM biopsy Mutation not detected or not available Mutation detected
BM biopsy may be needed in the future; continue to monitor patient


MPCM/UP, maculopapular cutaneous mastocytosis/UP. Figure adapted from Zanotti R, et al. J Clin Med. 2021;10(7):1420.


Classifying Subtypes of NonAdvSM 2022 WHO Criteria



SM diagnostic criteria met
0 B findings
• Absence of skin lesions
• BM involvement
• Serum tryptase <125 ng/mL







0 or 1 B finding
• Skin lesions may be present
≥2 B findings, 0 C findings
• Does not meet criteria for AHN

B Findings
• MCs in BM ≥30% and/or serum tryptase ≥200 ng/mL and/or KIT D816V with VAF ≥10% in BM or PB leukocytes
• BM hypercellularity or dysplasia or myeloproliferation in a non-MC lineage
• Organomegaly (without organ impairments)
Khoury JD, et al. Leukemia. 2022;36(7):1703-1719; NCCN. https://www.nccn.org/professionals/physician_gls/pdf/mastocytosis.pdf; Zanotti R, et al. Leukemia. 2022;36(2):516-524.
Differential Diagnosis
Hereditary α-Tryptasemia (HαT)
• ≈6% of general population, accounting for 90% of cases with elevated BST levels1
• Affects ≈12% to 17% of patients with SM2
– HαT+ patients with SM have a higher rate of mediator-related symptoms and severe anaphyhlaxis3-5
– Important to genotype when BST elevated6
– ≈9- to 10-ng/mL increase in tryptase for every extra copy of TPSAB11
Chromosome 167
Predicting HαT8 • Expected level of tryptase can be calculated via p13.3
Duplication

1 + extra copy numbers of TPSAB1
TPSAB1, tryptase alpha/beta 1; TPSB2, tryptase beta 2; TPSD1, tryptase delta 1; TPSG1, tryptase gamma 1. 1. Glover SC, et al. Ann Allergy Asthma Immunol. 2021;127(6):638-647; 2. Polivka L, et al. J Allergy Clin Immunol. 2024;153(1):349-353.e4; 3. Lyons JJ, et al. J Allergy Clin Immunol. 2021;147(2):622-632; 4. Crupi F, et al. Front Allergy. 2025;6:1592001; 5. Koch D, et al. Presented at: American Society of Hematology Annual Meeting; December 6-9, 2025; Orlando, FL. Abstract 25-8703; 6. McMurray JC, et al. Front Allergy. 2025;6:1599358; 7. Lyons JJ. Immunol Allergy Clin North Am. 2018;38(3):483-495; 8. NCCN. https://www.nccn.org/professionals/physician_gls/pdf/mastocytosis.pdf.

Differential Diagnosis
Other Conditions to Consider
• Idiopathic MCAS1,2
• Chronic idiopathic urticaria1,3,a
• hEDS4
• Neuroendocrine tumors, carcinoids (eg, pheochromocytoma)2,3,5
• Atypical infections—delayed immune dysregulation (eg, long COVID)6
• Cardiovascular (eg, coronary hypersensitivity,3,a postural orthostatic tachycardia syndrome,3 syncope7)
• Digestive (eg, adverse food reaction,3,a celiac disease,8 GERD,3 gluten enteropathy,8 IBS3)
• Neurologic (eg, anxiety,3 chronic fatigue syndrome,3 depression,8 fibromyalgia,8 headaches3)
GERD, gastroesophageal reflux disease; hEDS, hypermobile Ehlers -Danlos syndrome; IBS, irritable bowel syndrome; MCAS, mast cell activation syndrome.
aLocalized MC activation can occur.
1. Leru PM, et al. Exp Ther Med. 2020;20(3):2348-2351; 2. Rare Disease Advisor. https://www.rarediseaseadvisor.com/disease-info-pages/systemic-mastocytosis-differential-diagnosis/; 3. Theoharides TC, et al. N Engl J Med. 2015;373(2):163-172; 4. Monaco A, et al. Immunol Res. 2022;70(4):419-431; 5. Picard M, et al. Clin Ther. 2013;35(5):548-562; 6. Dr. Matthew Giannetti and Dr. Tsewang Tashi, personal communication; 7. Theoharides TC, et al. Expert Rev Clin Immunol. 2019;15(6):639-656; 8. Scherber RM, Borate U. Br J Haematol. 2018;180(1):11-23.
Christina BM Biopsy Results
• BM aspirate, slight increase in MCs (4% total), with 70% spindle-shaped and 30% mature round/oval forms
• BM biopsy, few dense multifocal aggregates with >15 MCs
– MCs in the aggregates were CD25+, CD117+, tryptase+, CD30−, with abnormal, spindle-shaped morphology; overall MC burden is 10%
• Diagnosis: ISM








Images courtesy of Anton Rets, MD, PhD.
Next Steps for Christina
• Diagnosis: ISM
• Referral to specialized center with expertise in mastocytosis
• Counsel regarding signs and symptoms of disease
• Avoid known triggers of MC activation
• Carry injectable epinephrine (2 autoinjectors) to manage anaphylaxis
Recommended for all patients with SM, regardless of subtype1
1. NCCN. https://www.nccn.org/professionals/physician_gls/pdf/mastocytosis.pdf; 2. Valent P, et al. J Allergy Clin Immunol Pract. 2022;10(8):1999-2012.


Known Triggers for MC Activation Events 1,2
Triggers Examples
Venoms
IgE Mediated
Food & beveragesb
Allergens
MRGPRX2 Medications
Cyclooxygenase
Inhibition

Medications
Acute infection
Pain
Environment
Stressors
Fatigue
Physical triggers
Surgery
Bee, wasp,3,a mixed vespids, fire ants
Pollen, pet dander, dust mites
Opioids, some antibiotics (eg, vancomycin), contrast dyes
NSAIDs
Viral, bacterial, fungal
Emotional, physical
Heat, cold, sudden changes in temperature, natural and chemical odors, sun/sunlight
Lack of sleep/sleep deprivation
Mechanical irritation, friction, vibration, exercise
Anesthesia (eg, atracurium)
Proceduresc Colonoscopy, endoscopy, interventional radiology
Vaccinations
IgE, immunoglobulin E; MRGPRX2, Mas-related G-protein coupled receptor member X2; NSAID, nonsteroidal anti-inflammatory drug.
aHymenoptera venom was recently identified as the most common trigger in ISM; bAlcohol consumption can induce a reaction, but the reaction is not IgE mediated; cPerioperative management should be considered.
1. Adapted from National Comprehensive Cancer Network (NCCN). https://www.nccn.org/professionals/physician_gls/pdf/mastocytosis.pdf; 2. Rama TA, Castells M. Curr Treat Options Allergy. 2023;10:442-457; 3. Niedoszytko M, et al. Allergy. 2024;79(9):2470-2481.
Pitfalls in SM Diagnostic Criteria

• BST variability: – HαT1 – Tryptase is not reliable when AHN is present: neoplastic myeloid cells may also express and release tryptase2
– Tryptase <20 ng/mL does not rule out SM1
• Negative KIT D816V in PB does not rule out SM3

– Often negative even by high-sensitivity methods when MC burden is low • Be aware of overlapping findings between MMAS and SM4
monoclonal mast cell activation syndrome.
Boggs NA, et al. Blood Adv. 2023;7(13):3150-3154;
Akin C, et al. Nat Rev Dis Primers. 2025;11(1):30; 3. Arock M, et al. Leukemia. 2015;29(6)1223-1232;
CASE 1: Treatment of NonAdv SM
Dr. Chernak



NCCN Guidelines® for MC Mediator Symptom–Directed Treatment Strategies1
Organ Involvement/Symptom
Skin: pruritus, flushing, urticaria, angioedema dermatographisma
First Line Additional Treatments
2. Leukotriene receptor antagonist

GI: abdominal pain, cramping, diarrhea, GERD/heartburn, nausea, vomiting
Hypotensive episodes/Anaphylaxis
Cardiovascular/Pulmonary: presyncope, tachycardia, wheezing, throat swelling
Osteopenia/Osteoporosis
Neurologic: headache, cognitive impairment (eg, brain fog, poor concentration and memory), depression
H1R and H2R antagonists
H2R antagonists
Epinephrine IM (acutely), supine positioning
H1R and H2R antagonists
Supplemental calcium and vitamin D, bisphosphonate; bone mineral density assessment
H1R and H2R antagonists
3. Aspirinb
4. Ketotifen
5. Cromolyn sodium, topical
2. Cromolyn sodium
3. Proton pump inhibitor
4. Leukotriene receptor antagonist
5. Ketotifen
Prevention: VIT, Rush desensitization, omalizumabc
2. Corticosteroids
3. Omalizumab
Denosumab, interferon-α inhibitor, cytoreductive agent; vertebroplasty/kyphoplasty
2. Cromolyn sodium
3. Aspirinb
4. Ketotifen
More than 50% of patients with SM take ≥3 prescription medications and ≥3 OTC medications.2
H, histamine; IM, intramuscular; NCCN, National Comprehensive Cancer Network; OTC, over the counter; VIT, venom immunotherapy.
aPsoralen and ultraviolet A (PUVA) therapy can improve cutaneous manifestations of SM, in some cases resulting in disappearance of skin lesions; however, lesions recur with cessation of treatment; bSome patients with SM will have an anaphylactic reaction to aspirin; its use should be closely supervised, with a graded dosing schedule3; cOmalizumab is not FDA approved for SM or recurrent anaphylaxis. Omalizumab is FDA approved to treat moderate to severe persistent allergic asthma (age ≥6 months), IgE-mediated food allergy (age ≥1 year), chronic rhinosinusitis with nasal polyps (age ≥18 years), and chronic spontaneous urticaria (age ≥18 years). NCCN. https://www.nccn.org/professionals/physician_gls/pdf/mastocytosis.pdf; 2. Mesa RA, et al. Cancer. 2022;128(20):3691-3699; 3. Pardanani A. Blood. 2013;121(16):3085-3094.
Treatment Recommended for Christina


• Cetirizine: 20 mg twice daily (BID)
• Famotidine: 40 mg BID

NCCN. https://www.nccn.org/professionals/physician_gls/pdf/mastocytosis.pdf.


Christina
• Over the past 4 years, BST has consistently increased

• Symptom burden has significantly increased, with intermittent bone pain and 1 vertebral fracture, without an associated osteolytic lesion
• Despite H1/H2 antihistamines, cromolyn sodium, ketotifen, and leukotriene modifiers added over time, she continues to experience fatigue, GI distress, flushing, and reduced QoL
• TSS, 85

QoL and Symptom Assessment Tools
• Symptom assessment:
– Direct questions about symptom response to treatment
– Validated tools used in clinical trials:
• Mastocytosis Symptom Assessment Form (MSAF)1
• Mastocytosis Activity Score (MAS)2
• ISM Symptom Assessment Form (ISM-SAF©)3
• Mastocytosis Symptom Severity Daily Diary (MS2D2)4
• QoL:
– Mastocytosis Quality-of-Life Questionnaire (MQLQ)1
– Mastocytosis Quality of Life Questionnaire (MC-QoL)5
ISM Symptom Scoring
Abdominal pain
Diarrheaa Nausea
Spots
Itching
Flushing
Brain fog
Headache
Dizziness
Bone pain
Fatigue
Symptoms scored daily over a 24-hour recall period
0 = no symptom 10 = worst imaginable symptom

TSS (0-110)
≥28 indicates moderate to severe symptoms
HRQoL, health-related quality of life; OTC, over the counter; QoL, quality of life.
aDiarrhea frequency is scored separately but contributes to total score.
1. NCCN. https://www.nccn.org/professionals/physician_gls/pdf/mastocytosis.pdf; 2. Siebenhaar F, et al. Allergy. 2018;73(7):1489-1496; 3. Taylor F, et al. Orphanet J Rare Dis. 2021;16(1):414; 4. Marcus J, et al. Value Health. 2025;28(6 suppl 1):S342-S343; 5. Siebenhaar F, et al. Allergy. 2016;71(6):869-877.
Treatment Approaches of NonAdvSM

Nonadv SM

BMM/ISM/SSM

• Avoid triggers
• Carry epinephrine autoinjector

No symptoms Symptoms

Watch and wait

aPlatelets >50×109/L.
Adapted from Ustun C, et al. Blood Adv. 2025;9(9):2048-2062.


• H1/H2 antihistamines
• Anti-IgE antibody
• Cromolyn
• Leukotriene receptor antagonist
• VIT If not successfully managed

• KIT-targeting TKI
– Avapritiniba
– Midostaurin
• Clinical trial
• Cladribine


Tyrosine Kinase Inhibition Targeting SM Pathophysiology
• Usually target active site of the kinase receptor1
• Classified based on type of binding (eg, competitive, allosteric)
• KIT inhibitors:
– Imatinib: inhibits KIT WT or non-D816V mutations2
• Inhibits ABL1, FLT3, CSFR1, PDGFRα/β2
• WDSM may respond to it3
– Morphologic variant across all subtypes of SM, usually characterized by round MCs that are CD30+ and KIT mutation negative
– Midostaurin: inhibits KIT WT and D816V2
– Avapritinib,a bezuclastinib, elenestinib: selectively inhibit KIT D816V2
• Potential for overlap in inhibition (eg, avapritinib inhibits KIT and PDGFRα mutants4)





binding domain




ABL1, ABL proto-oncogene 1, non-receptor tyrosine kinase; ATP, adenosine triphosphate; FLT3, FMS-like tyrosine kinase 3; CSFR1, colony-stimulating factor 1 receptor; WDSM, well-differentiated SM; WT, wild type. aAvapritinib is the only TKI currently FDA approved to treat ISM. 1. Pottier C, et al. Cancers. 2020;12(3):731; 2. Akin C. Immunol Allergy Clin North Am. 2023;43(4):743-750; 3. Álvarez-Twose, et al. Allergy Clin Immunol. 2016;137(1):168-178.e1; 4. Trullas-Jimeno A, et al. ESMO Open. 2021;6(3):100159.
Avapritinib Met Primary Endpoint in Patients With ISM
Phase 2 PIONEER Trial
Avapritinib
Significantly


TSS1


Avapritinib Met
Key Secondary Endpoints in Patients With ISM Phase 2 PIONEER Trial
in Clinical Markers and Symptoms
Long-Term Efficacy
of Avapritinib in Patients With ISM
• With a median 2-year follow-up, avapritinib 25 mg QD demonstrated sustained improvements in: – TSS and all 11 individual symptom scores, with the greatest improvements in spots, itching, flushing, and fatigue
– MC-QoL total score and all 4 health domain scores, with the greatest improvement in the social life/functioning domain
QD, once daily. Castells M, et al. J Allergy Clin Immunol Pract. 2025;13(8):2194-2196.e1.


Avapritinib for ISM
What Clinicians Need to Know
• 25 mg orally QD on an empty stomach1
– CONTRAINDICATED for patients with platelet count <50×109/L or pregnant
• Avoid coadministration with strong and moderate CYP3A inhibitors and inducers1
• AEs: peripheral and periorbital edema, dizziness, flushing, photosensitivity1
– Intracranial bleeding has not been reported in patients with ISM who are taking avapritinib1,a
• Ensure patient does not have a history of intracranial hemorrhage before prescribing
• Avapritinib was well tolerated in patients receiving concomitant omalizumab, similar to overall avapritinibtreated PIONEER part 2 population2
AE, adverse event; CYP, cytochrome P450.
aAs of November 11, 2025.
1. Drugs@FDA. https://www.accessdata.fda.gov/drugsatfda_docs/label/2023/212608s013lbl.pdf; 2. Akin C, et al. Ann Allergy Asthma Immunol. 2024;133(suppl 6):S83.


Investigational Agents in NonAdvSM

















































Bezuclastinib2,3 Phase 2 (Summit)
2 Phase 2/3 (HARBOR) Masitinib2 Phase 3
TL-8954 Phase 2
BTK, Bruton tyrosine kinase; C, complement; siglec-8, sialic acid-binding Ig-like lectin 8. 1. Figure adapted from Castells M, Akin C. Nat Med. 2021;27(12):2081-2082; 2. Nicolosi M, et al. Medicina (Kaunas). 2021;57(11):1135; 3. Akin C, et al. Blood. 2022;140(suppl 1):6838-6839; 4. ClinicalTrials.gov. https://clinicaltrials.gov/study/NCT04655118.
Bezuclastinib
Summit (ISM and SSM)
• Minimal CNS penetration1
• High selectivity: does not inhibit PDGFRα/β, FLT3, CSFR12
• No treatment-related SAEs; majority of TEAEs at 100 mg QD were low grade and reversible1,3,4
– Transaminitis, no hospitalizations resulted4
– No bleeding or cognitive impairment events reported
• Part 2: 24-week treatment5
• Enrollment closed3

CNS, central nervous system; SAE, serious adverse event; TEAE, treatment-emergent AE.
1. Bose P, et al. Blood. 2023;142(suppl 1):77; 2. Akin C. Immunol Allergy Clin North Am. 2023;43(4):743-750; 3. Rein LAM, et al. Blood. 2024;144(suppl 1):4556; 4. Rein LAM, et al. Presented at: American Society of Hematology Annual Meeting. December 6-9,2025; Orlando, Fl. Abstract abs25-1953; 5. Modena B, et al. J Allergy Clin Immunol. 2024;153(suppl 2):AB224.
Bezuclastinib

Improvements After 24 Weeks of Treatment


Elenestinib Phase 2/3 HARBOR Trial Part 1 (ISM)
• Limited CNS penetration1
• Selectively inhibits KIT D816V; does not inhibit WT KIT1
• Primary endpoints: safety, PK, PD1
– Well tolerated at all dose levels for 35 weeks (median)
– No treatment-related SAEs or AEs that led to drug discontinuation
• Part 2 actively enrolling2

Significant Dose-Dependent Improvements After 12 Weeks of Elenestinib1,3
Secondary Endpoints
Mean Percentage Change From Baselinea

Routine Monitoring NonAdvSM
• Patients with ISMa (annually1) and stable SSMa (every 6 -12 months1) should be monitored for changes in:
KIT VAF (when clinically indicated)
Physical examination, including skin/lesions3
QoL/Symptom burden1
• DEXA scan every 1 to 3 years for patients with osteopenia/osteoporosis1,b
• Monitoring with avapritinib use in ISM: lab monitoring (CMP, CBC/Diff) and visits at 3 and 6 months after starting medication, then every 6 months

If laboratory results or symptoms change, therapeutic adjustment should be considered.
aPatients with unstable SSM or ISM should be seen more frequently until stabilized; Patients with BMM are at higher risk for osteopenia/osteoporosis. 1. NCCN. https://www.nccn.org/professionals/physician_gls/pdf/mastocytosis.pdf; 2. Siebenhaar F, et al. Allergo J Int. 2025;34:57-68.
Instructions for Christina


• Avapritinib: 25 mg QD
• Monitoring with initiation of avapritinib for ISM: lab monitoring (CMP, CBC/Diff) and visits at 3 and 6 months after starting medication, then every 6 months
• Alert treating clinician to any changes
• Always carry 2 epinephrine autoinjectors and avoid triggers


CASE 2: Diagnosing and Treating AdvSM


Dr. Tashi




• 71-year-old man
• Recent testing by PCP
– WBC: 6.15 ×109/L; Hb: 9.5 g/dl; Platelets: 115 ×109/L
– Differential:
• ANC: 3100 cells/μL
• Absolute monocyte count: 1220 cells/μL
• Absolute eosinophil count: 1550 cells/μL
• Myelocytes: 3%
• Metamyelocyte: 3%
• Referred to Hem/Onc for further evaluation


Bob Hem/Onc Clinic Visit

• Presenting symptoms:
– Progressive fatigue and exertional dyspnea
– Lack of exercise tolerance, mild nausea, and bloating
– Left upper quadrant fullness
– 8 lb. weight loss over ≈6 months
• Past Medical History:
– Hypertension (on amlodipine, lisinopril)
– Hypothyroidism (on levothyroxine)
• No history of smoking or alcohol use
• Physical exam
– Mildly pale conjunctiva
– Skin: no lesions


– Palpable spleen, ≈5 cm below the LCM


Labs, CT and BM biopsy ordered.
Bob
Hem/Onc Testing Results


Imaging
• Mild hepatomegaly (17cm)
• Splenomegaly (18 cm craniocaudal)
• Mild ascites, no focal lesions



Bob Hem/Onc Testing Results


Laboratory Findings
– WBC: 5.86 ×109/L; Hb 9.6 g/dl; Platelets 110 ×109/L
– Differential:
• ANC: 2800 cells/μL
• Monocytes: 21%
• Eosinophils: 17%
• Metamyelocytes and myelocytes: 2%
– BST, 179 μg/L



BM Biopsy
Bob Hem/Onc Testing Results


– Hypercellular marrow – 95% with trilineage hematopoiesis, ≈50% MCs, with diffuse dense aggregates
– Dysmegakaryopoiesis and dyserythropoiesis, monocytosis
– KIT D816V+, VAF: 19%
– Flow cytometry: CD117+, CD25+; weak CD2+, CD30+; increased eosinophils and monocytes
– NGS: positive for mutations: TET2 frameshift, SRSF2 P95L, SETBP1
A868T, CBL W590*

Core Biopsy











Images courtesy of Tsewang Tashi,

Classifying Subtypes of AdvSM 2022 WHO Criteria


SM diagnostic criteria met
C Findings




≥1 C finding
• Does not meet criteria for AHN
WHO criteria for AHN met (eg, dysplasia, monocytosis, eosinophilia)
• AML, CMML, MDS, MPN, lymphoma, other
MCLa




≥20% MCs on BM aspirate smear
• Classic MCL: ≥10% MCs in PB smear
• Aleukemic MCLb : <10% MCs in PB smear



• Osteolytic lesions (≥2 cm) or pathologic fractures
• Malabsorption with weight loss with hypoalbuminemia
• Any other life-threatening end-organ damage
Chris meets the SM diagnostic criteria (MC aggregates, CD25+ , KIT D816V+ ).
Diagnosis: AdvSM, SM-AHN with chronic myelomonocytic leukemia (CMML).
ANC, absolute neutrophil count; CMML, chronic myelomonocytic leukemia.
aB and C findings possible; in acute MCL, C findings are detectable; bMore common than leukemic MCL.
Khoury JD, et al. Leukemia. 2022;36(7):1703-1719; NCCN. https://www.nccn.org/professionals/physician_gls/pdf/mastocytosis.pdf.
• Avoid triggers
• Carry epinephrine autoinjector

Treatment Approaches for AdvSM


If experiencing mediatorrelated symptoms
• H1/H2 antihistamines
• Anti-IgE antibody
• Cromolyn
• Leukotriene receptor antagonist
• VIT





HSCT, hematopoietic stem cell transplant.
• KIT-targeting TKI
– Avapritiniba
– Midostaurin
– Clinical trial
• Cladribine
• Imatinib for WDSM/non-KIT D816V




aPlatelets >50×109/L; bShould only be considered in AdvSM. Figure adapted from Ustun C, et al. Blood Adv. 2025; 9(9):2048-2062; Veitch S, Radia D. Diagnostics. 2024;14(1):80.



AHN-directed therapy +/- KITtargeting TKI based on treatment priority




Management of AHN and Challenges

• Typically, SM and AHN portions are treated separately, as if the other does not exist
• Which to treat first depends on the primary cause of the symptoms and organ damage; often it may be difficult to discern which one is the cause
• Unless the AHN needs immediate therapy, treating SM is easier for causal attribution than treating the AHN with HMA or other chemotherapies
• Combination therapies of HMA or other AHN therapies with KIT inhibitors have not been studied
– Midostaurin data available from AML studies
• Encourage patients to enroll in clinical trials
• Refer to Mastocytosis Center of Excellence
HMA, hypomethylating agent.
Courtesy of Tsewang Tashi, MD.
FDA-Approved TKIs for AdvSM

Avapritinib
FDA Indications Notes
Adult patients with AdvSM, including ASM, SM-AHN, MCL1
• First-line treatment (if KIT D816V)2
• Most frequent AEs: edema, diarrhea, nausea, fatigue1
Imatinib
Midostaurin
Adult patients with ASM without the KIT D816V mutation or with KIT mutational status unknown3
• Effective for WDSM, non-KIT mutants4
• Most frequent AEs: edema, nausea, vomiting, muscle cramps, musculoskeletal pain, diarrhea, rash, fatigue, and abdominal pain3
Adult patients with AdvSM, including ASM, SM-AHN, MCL6
• Most frequent AEs: nausea, vomiting, diarrhea, edema, musculoskeletal pain, abdominal pain, fatigue, upper respiratory tract infection, constipation, pyrexia, headache, and dyspnea6
1. Drugs@FDA. https://www.accessdata.fda.gov/drugsatfda_docs/label/2024/212608s020lbl.pdf; 2. Akin C, et al. Nat Rev Dis Primers. 2025;11(1):30; 3. Drugs@FDA. https://www.accessdata.fda.gov/drugsatfda_docs/label/2022/021588s062lbl.pdf; 4. NCCN. https://www.nccn.org/professionals/physician_gls/pdf/mastocytosis.pdf; 6. Drugs@FDA. https://www.accessdata.fda.gov/drugsatfda_docs/label/2023/207997s010lbl.pdf.
TKI Clinical Trial Results for AdvSM

(Currently in Part 2)
mIWG-MRT-ECNM, modified International Working Group-Myeloproliferative Neoplasms Research and Treatment and European Competence Network on Mastocytosis; DOR, duration of response; NR, not reached; ORR, overall response rate.
aPooled analysis of N=31 response evaluable patients with AdvSM who received ≥1 systemic therapy prior to avapritinib and initiated avapritinib 200 mg QD in the EXPLORER or PATHFINDER studi es; bAdjudicated using mIWG-MRT-ECNM criteria; cN=28 adults treated for ASM; dN=89 adults ≥18 years of age with ASM, SM-AHN, or MCL according to WHO criteria (with measurable C findings) received open-label 100 mg oral midostaurin BID in 4-week continuous cycles. Concurrent antineoplastic therapy was not allowed; eResponse rate measured with modified Valent and Cheson criteria; fN=38 patients with AdvSM (aged 48-76 years) were treated with midostaurin 100 mg BID; gN=32 patients with AdvSM confirmed by central adjudication were randomized and dosed with bezuclastinib 50mg BID (n=8), 100mg BID (n=7), 200mg BID (n=8), or 400mg QD (n=9); hORR calculated using mIWG-MRT-ECNM criteria.
1. Reiter A, et al. Blood Adv. 2022;6(21): 5750-5762; 2. Drugs@FDA. https://www.accessdata.fda.gov/drugsatfda_docs/label/2022/021588s062lbl.pdf; 3. Gotlib J, et al. N Engl J Med. 2016;374:2530-41; 4. Jawhar M, et al. Blood. 2017;130(2)137-145; 5. DeAngelo DJ, et al. Blood. 2024;144(suppl 1):659-661; 6. Chifotides H, Bose P. Clin Lymphoma Myeloma Leuk. 2025;25(1):1-12.
EXPLORER
Avapritinib Clinical Trial Data in AdvSM
Mean Change From Baseline

CR, complete remission; CRh, complete remission with partial recovery of PB counts.
aN=69 patients with centrally confirmed AdvSM were administered avapritinib at doses of 30-400mg QD; 200 mg and 300 mg dosages were studied in dose-expansion cohorts; bN=62 patients with prospectively centrally adjudicated AdvSM were enrolled (ASM [n=9], SM-AHN [n=43], and MCL [n=10]) who received avapritinib at a starting dose of 200 mg QD (n=60, 2 patients started at 100mg QD); avapritinib was administered continuously in 28-day cycles until progression, intolerance, withdrawal by the investigator or patient, or death; cAdjudicated using mIWG-MRT-ECNM criteria.
1. DeAngelo DJ, et al. Nat Med. 2021;27(12):2183–2191; 2. Gotlib J, et al. Nat Med. 2021;27(12):2192-2199; 3. Reiter A, et al. Presented at:
Association Congress; June 13-16, 2024; Madrid, Spain. Abstract S224.
Avapritinib vs Midostaurin or Cladribine
Unweighted OS for Avapritinib vs Midostaurin or Cladribinea

Avapritinib vs Midostaurin
vs Cladribine
1L, first line; 2L, second line; BAT, best available therapy; MARS, Mutation-Adjusted Risk Score.
aThis study used pooled individual patient data from the phase 1 EXPLORER and phase 2 PATHFINDER trials with a data cutoff date of April 20, 2021. In EXPLORER, patients were treated at different avapritinib starting doses, ranging from 30 to 400 mg QD while in PATHFINDER, all patients received an avapritinib starting dose of 200 mg QD. The primary analysis included patients who initiated avapritinib at any dose. In the pooled sample, median follow-up time for OS was 17.1 months. Avapritinib cohort n=176 patients included in the EXPLORER (n=69) and PATHFINDER (n=107) trials. Midostaurin cohort n=94
and
Additional Mutations in Myeloid Target Genes
in Patients With AdvSM
• Prevalence of additional mutations in myeloid target genes in patients with AdvSM is up to 90%
– Most frequently affected genes include SRSF2, ASXL1, RUNX1, TET2, and CBL
• Mutated genes in the “S/A/R panel” (SRSF2, ASXL1, RUNX1) are considered to be high-risk mutations
– S/A/R mutations, CBL, and/or EZH2 are associated with inferior survival in AdvSM
– Other genetic defects have also been described, albeit at much lower frequency
– Both the type and number of mutations may affect the patient’s overall outcome

C, et al. Nat Rev Dis Primers. 2025;11(1):30.
• Only percentage of MCs (≥20%) in BM aspirate smear or PB smear, not BM biopsy sections, qualifies as an MCL criterion1
– In patients with C-findings: acute MCL1
• MCs are atypical and immature1
• Affects majority of patients2
– In patients without C-findings: chronic MCL1
• MCs are often mature and may even show a well-differentiated morphology1
– Prognosis of patients with chronic MCL is better than for those with acute MCL, although chronic MCL may also transform into acute MCL after some time1



When Are Chemotherapy and HSCT the Appropriate for SM-AHN?

• Decisions on HSCT in SM-AHN is mainly driven by the AHN
• Chemotherapy agents are AHN-specific (eg, HMA or HMA/Ven as for MDS/CMML/AML, JAK inhibitors)
• HSCT should be considered in patients with rapidly progressing:
– SM-AHN, TKI-resistant-ASM or -MCL
– Recent registry analysis: outcome of HSCT in AdvSM correlated with disease subtype and treatment response of SM or AHN before transplant; deeper responses = better HSCT outcomes
Ven, venetoclax. Akin C, et al. Nat Rev Dis Primers. 2025;11(1):30.
SM-AHN—Progression of AHN

• KIT inhibitor therapy is effective for SM but its effect on AHN remains unclear
– May delay progression, as reduction in monocytosis is seen in CMML in avapritinib trials1
• In midostaurin trial, rate of leukemic transformation was 11% (n=13)2
• In the PATHFINDER trial with avapritinib, at 3-year follow-up, progression rate was 14% and majority was in AHN portion1
• High risk of transformation if:3
– Presence of S/A/R mutations
– Acquisition of new mutations in K/NRAS, RUNX1, and IDH2
1. Reiter A, et al. Presented at: European Hematology Association Congress; June 13-16, 2024; Madrid, Spain. Abstract S224; 2. Gotlib J, et al. N Engl J Med. 2016;374:2530-2541; 3. Akin C, et al. Nat Rev Dis Primers. 2025;11(1):30.
Routine Monitoring AdvSM

• CBC/Diff
• CMP
• Serum tryptase levels
• BM aspirate and biopsy with cytogenetics
– For SM as well as AHN assessment
• KIT D816V ddPCR and myeloid NGS panel
– Follow existing mutations’ VAF and any new mutations
• Imaging/biopsy of extramedullary organ to assess SM-related organ damage (response assessment of C-finding)
• DEXA scan (if osteopenia or osteoporosis at diagnosis)
2025. https://www.nccn.org/professionals/physician_gls/pdf/mastocytosis.pdf.
Next Steps for Bob

ü Avapritinib: 200 mg QD

– Platelet counts must be monitored when initiating avapritinib for patients with AdvSM1
• Prior to initiating therapy: must be >50×109/L
• Q2W for the first 8 weeks regardless of baseline platelet count
– Monitor as clinically indicated if values are greater than 100×109 /L
– Manage platelet counts of <50×109/L by treatment interruption or dose reduction
ü Monitor the AHN for progression
ü BM biopsy every 3-6 months as clinically indicated
ü Depending on the type of AHN, start conversation on HSCT if eligible



LONG-TERM CARE PLANNING ACROSS THE SM CONTINUUM


Dr. Chernak


Potential Predictors of Poor Prognosis in SM
Overall AdvSM
• Disease subtype1
• Age: >60 years1
• Hemoglobin: <10 g/dL1
• Platelets: <100/150×109/L1,a
• BST level2
• ≥6% VAF of KIT D816V in PB3
• Elevated serum AP (≥100 U/L)4
• High symptom burden5

• Other genetic mutations2 (eg, S/A/R)
• Eosinophilia1
• Splenomegaly1
• Cytopenias, leukocytosis6
Progression to more severe subtypes occurs in ≈1% to 3% of cases7
Different prognostic scoring systems can be used to predict prognosis. 1
aDependent on whether MARS for advanced SM or MAPS for mastocytosis is used. 1. NCCN. https://www.nccn.org/professionals/physician_gls/pdf/mastocytosis.pdf; 2. Valent P, et al. J Allergy Clin Immunol Pract. 2022;10(8):1999-2012; 3. Maurer M, et al. J Allergy Clin Immunol. 2024;153(2):AB238; 4. Mukherjee S, et al. Blood. 2023;142(suppl 1):6406; 5. Reiter A, et al. Blood. 2020;135(16):1365-1376; 6. Lim K, et al. Blood. 2009;113(23):5727-5736; 7. Sizemore JA, et al. J Am Acad Dermatol. 2025. [Epub ahead of print].
Patient Education Is Critical to Successful Management
• Trigger avoidance1
– Identification of potential triggers
– Unpredictability of response
• Periprocedural precautions1,2
– Consult with anesthesia and surgical teams
– Review prior anesthesia records • Anaphylaxis action plan1 • ED response plan1 • Medication adherence1
The Mast Cell Disease Society (TMS)1
Patient education and resources (eg, reference guides on treatment, ED plan, support groups)





NCCN Guidelines for Patients® Systemic Mastocytosis, 2025
TMS provides multifaceted support to patients, families, and medical professionals through education, advocacy, and collaboration.
GARD helps patients find information, services, experts, financial aid, and support groups.
NORD is a patient advocacy organization committed to the identification, treatment, and cure of rare disorders through programs of education, advocacy, research, and patient services.



AIM is a group dedicated to advancing the research, education, and treatment of mastocytosis and related mast cell diseases.
ECNM (European Competence Network on Mastocytosis) is a group dedicated to improving disease recognition, diagnosis, and therapy in patients with mastocytosis in Europe.

Medication Type
Medication Considerations in Patients With SM
Avoid or Use With Caution

General Medications
Pain Medications
• Alcohol
• Amphotericin B
• Dextran
• Dextromethorphan
• Polymyxin B
• Opioid narcotics (may be tolerated by some individuals)
• Ketorolac
• Atracurium
General Anesthetics
Local Anesthetics
• Doxacurium
• Benzocaine
• Chloroprocaine
Intraoperative Induction Medications
Inhaled Anesthetics
• Quinine
• Vancomycin IV
• Alpha-adrenergic blockers
• Beta-adrenergic blockers
• NSAIDs (unless the patient is already taking a drug from this class)
• Rocuronium
• Mivacurium
• Procaine
• Tetracaine
Medications That Are Typically Tolerated
• Calcium channel blockers
• Centrally-acting alpha 2 adrenergic stimulants
• Aldosterone antagonists
• Fentanyl (may require adjunctive treatment with ondansetron)
• Tramadol
• Pancuronium
• Vecuronium
• Bupivacaine
• Lidocaine
• Levobupivacaine
• Ketamine
• Midazolam
• Propofol
• Sevoflurane
• Mepivacaine
• Prilocaine
• Ropivacaine
IV, intravenous.
TMS. https://tmsforacure.org/wp-content/uploads/2023/03/TMS_Full-Patient-Guide_r6.pdf.
Conclusions

• SM spans a biologic continuum from indolent to advanced disease, most often driven by KIT D816V
• High-sensitivity molecular testing and accurate subtype classification are essential to guide prognosis and treatment selection
• Patients with ISM have a low risk of progression; symptom-directed therapy and trigger avoidance are critical
• Avapritinib, midostaurin, and emerging agents provide targeted benefit across SM subtypes
• Collaborative, patient-centered management integrating symptom control, pharmacotherapy, and long-term monitoring improves outcomes